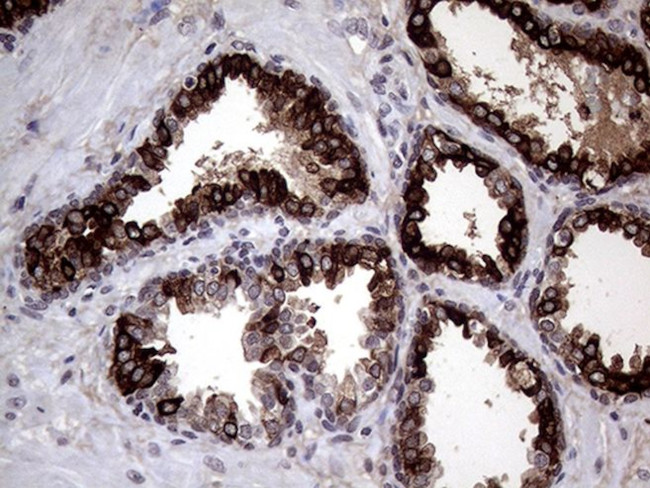
AGR2 Antibody in Immunohistochemistry (Paraffin) (IHC (P))

Search
OriGene
AGR2 Monoclonal Antibody (OTI5E10), TrueMAB™
{{$productOrderCtrl.translations['antibody.pdp.commerceCard.promotion.promotions']}}
{{$productOrderCtrl.translations['antibody.pdp.commerceCard.promotion.viewpromo']}}
{{$productOrderCtrl.translations['antibody.pdp.commerceCard.promotion.promocode']}}: {{promo.promoCode}} {{promo.promoTitle}} {{promo.promoDescription}}. {{$productOrderCtrl.translations['antibody.pdp.commerceCard.promotion.learnmore']}}
产品信息
CF809781
种属反应
宿主/亚型
分类
类型
克隆号
抗原
偶联物
形式
浓度
规格
纯化类型
保存液
内含物
保存条件
运输条件
产品详细信息
For reconstitution, we recommend adding 100 µL distilled water to a final antibody concentration of about 1 mg/mL. To use this carrier-free antibody for conjugation experiments, we strongly recommend performing another round of desalting. (Zeba Spin Desalting Columns, 7KMWCO, 0.5 mL, Product # 89882)
靶标信息
AGR2 (anterior gradient protein 2) and AGR3 are members of the anterior gradient homolog family. They are secreted cytoplasmic proteins which are involved in metastasis induction and p53 tumour supressor inhibition. They may serve as molecular markers and potential therapeutic targets for hormone-responsive breast tumours. AGR2 is ubiquitously expressed with upregulated expression in prostate cancer, breast cancer, lung cancer, renal carcinomas and endometrial carcinomas. AGR2 expression is positively correlated with that of the estrogen receptor (ER) and is negatively correlated with that of the epidermal growth factor receptor (EGFR).
仅用于科研。不用于诊断过程。未经明确授权不得转售。
篇参考文献 (0)
生物信息学
蛋白别名: AG-2; AGR2 SV-C; anterior gradient 2 homolog; anterior gradient homolog 2; Anterior gradient protein 2 homolog; epididymis secretory protein Li 116; HPC8; protein disulfide isomerase family A, member 17; Protein Gob-4; secreted cement gland homolog; Secreted cement gland protein XAG-2 homolog; unnamed protein product
基因别名: AG-2; AG2; AGR2; Agr2h; GOB-4; Gob4; HAG-2; HEL-S-116; HPC8; mAG-2; PDIA17; RIFTD; UNQ515/PRO1030; XAG-2
UniProt ID: (Human) O95994, (Mouse) O88312
Entrez Gene ID: (Human) 10551, (Mouse) 23795, (Rat) 298961